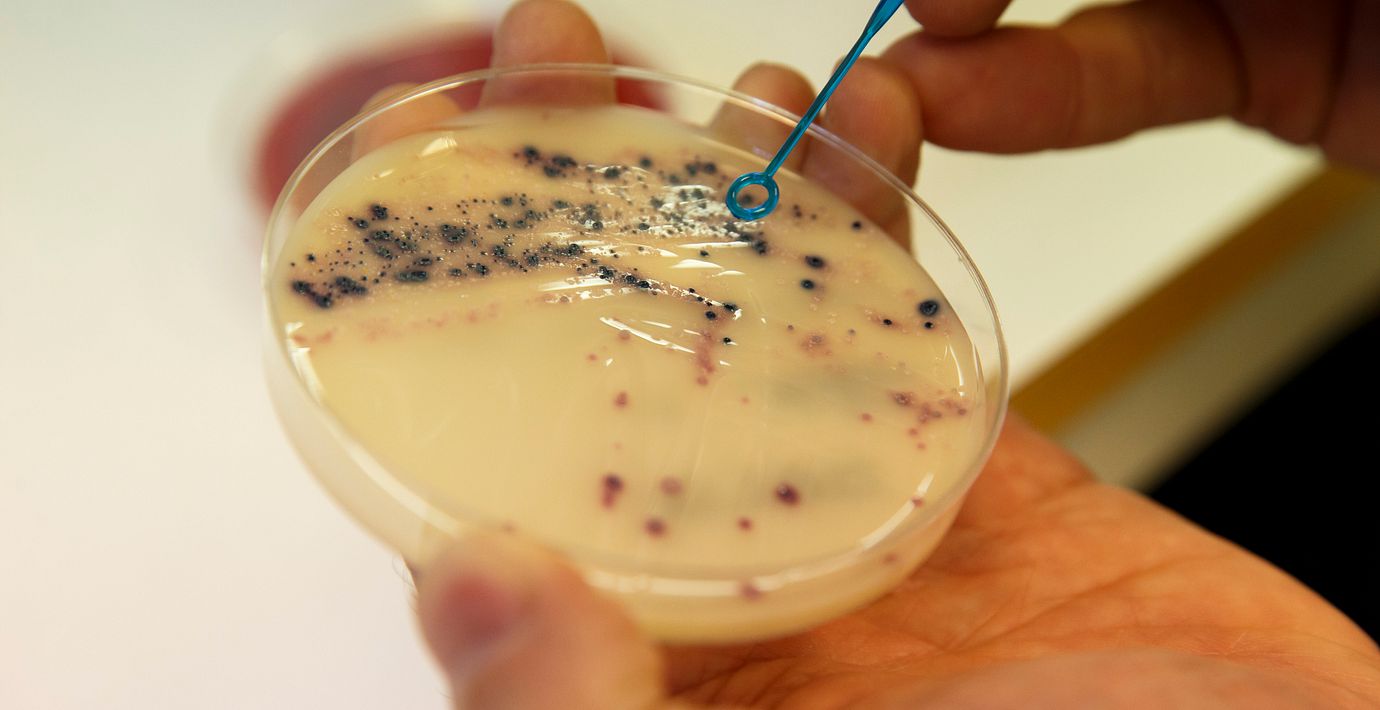

Fall av aggressiv bakterie har tredubblats i Sverige
En aggressiv multiresistent variant av E. coli-bakterien sprids nu snabbt i Europa. I Sverige har antalet fall tredubblats på nästan tio år, rapporterar SvD med hänvisning till statistik från Folkhälsomyndigheten.
Över 350 fall har rapporterats hittills i år, jämfört med drygt 100 fall under 2015.
Bakterien kan överföras via avföring eller mat och vatten. Bästa sättet att skydda sig är därför att tvätta händerna ordentligt och hålla en god underlivshygien, enligt Anders Sönnerborg, professor i infektionssjukdomar vid Karolinska Institutet. Och den som befinner sig utomlands kan med fördel välja gatukök framför en restaurangmåltid.
– Då kan man se att maten blir ordentligt upphettad, vilket dödar bakterierna. Det är svårare på restaurang, säger Sönnerborg.



